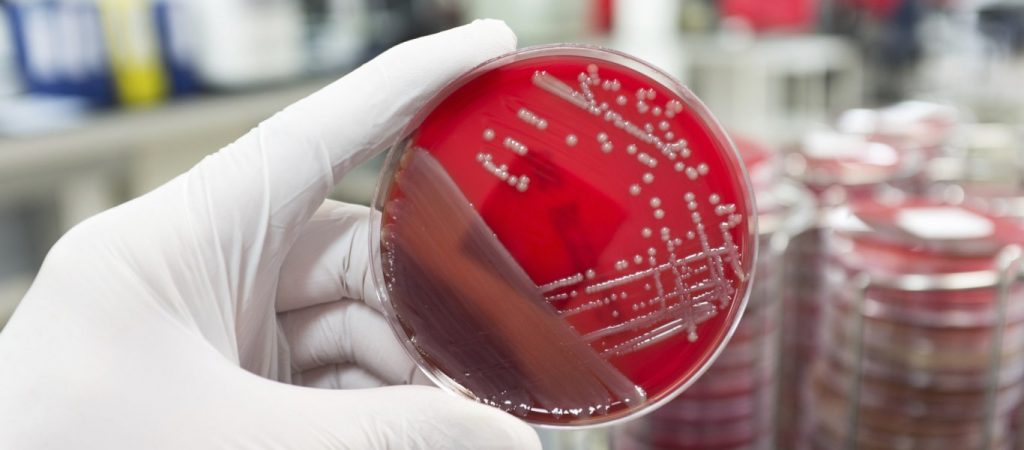

Σε κατάσταση συναγερμού έχει τεθεί το Κέντρο Ελέγχου Ασθενειών (CDC) των ΗΠΑ καθώς πλέον έχει επιβεβαιώσει 90 κρούσματα μιας εξαιρετικά επικίνδυνης ασθένειας σε 27 Πολιτείες.
Η ασθένεια ονομάζεται οξεία χαλαρή μυελίτιδα, η οποία προκαλεί παράλυση στους ασθενείς που πλήττει. Το CDC αναφέρει ότι εξετάζει συνολικά 162 περιπτώσεις σε όλες τις ΗΠΑ, καθώς υποψιάζεται ότι τα κρούσματα είναι
περισσότερα.
Η ασθένεια ονομάζεται οξεία χαλαρή μυελίτιδα, η οποία προκαλεί παράλυση στους ασθενείς που πλήττει. Το CDC αναφέρει ότι εξετάζει συνολικά 162 περιπτώσεις σε όλες τις ΗΠΑ, καθώς υποψιάζεται ότι τα κρούσματα είναι
περισσότερα.
Το ανησυχητικό είναι ότι το CDC ανέφερε ότι ακόμα δεν έχει εντοπίσει την αιτία που προκαλεί την ασθένεια, ενώ ακόμα δεν υπάρχει θεραπεία, με αποτέλεσμα τα θύματα είτε να αναρρώνουν μόνα τους είτε να παραμένουν παράλυτα.
pronews.gr
Από το katohika
loading...
Δεν υπάρχουν σχόλια:
Δημοσίευση σχολίου